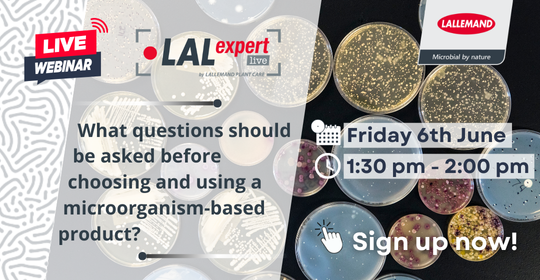
🌾 New LALEXPERT Webinar: Microbial Products in Agriculture – The Essentials.
🔍 This short webinar offers practical insights into key factors to help you make informed, science-based decisions.
👉 Register: events.teams.microsoft.com/event/1bc52841…
#AgWebinar #Biologicals #LallemandPlantCare

Lallemand Plant Care
@lallemand_pcare
#Microorganisms play a key role in plant health, nutrition & performance. We are one of the most innovative, best performing & trusted microorganism companies.
ID: 529234862
http://www.lallemandplantcare.com 19-03-2012 09:06:35
1,1K Tweet
1,1K Takipçi
1,1K Takip Edilen






🌱 Matinée Technique Perret | 4 avril à Clermont-Ferrand 📍 Retrouvez-nous pour parler #maraîchage, #horticulture et solutions microbiennes ! 🔬 📩 Inscription : [email protected] #Biocontrôle #AgTech #SantéDesPlantes #LallemandPlantCare


Sur le terrain 🌱 Nos équipes suivent la pression #Sclérotinia en colza avec le Kit pétales Terres Inovia LALSTOP Contans WG en action pour un biocontrôle durable ! #Colza #Biocontrôle #LallemandPlantCare









☀️🚴 Pause sportive pour Lallemand Plant Care : passage du Tour de France près de Castelmaurou ! Un moment convivial qui rappelle l’importance de l’esprit d’équipe et de la régularité, que ce soit en agriculture ou sur un vélo. #TourDeFrance #EspritDÉquipe Tour de France™ ⚡




🌱⚠️ En Alsace, des parcelles de tabac totalement ravagées par le sclérotinia. Aucune récolte possible. Agir à chaque étape est essentiel : rotation, surveillance, récolte rapide, et LALSTOP Contans WG ! 👉 lallemandplantcare.com/fr/france/prod… #LallemandPlantCare #Sclerotinia #Biocontrôle